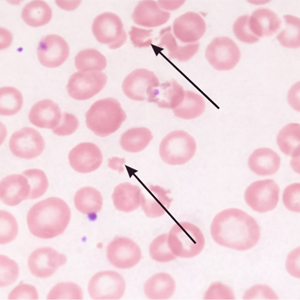
internal-ttp-signs A blood film from a patient with TTP showing relatively minor changes. Platelets are severely reduced and there are occasional red cell fragments (arrowed)

Thrombotic Thrombocytopenic Purpura (TTP) is a rare blood disorder. In TTP, blood clots form in small blood vessels throughout the body.
TTP also can cause red blood cells to break apart faster than the body can replace them. This leads to hemolytic anemia (HEE-moh-lit-ick uh-NEE-me-uh)—a rare form of anemia. Anemia is a condition in which the body has a lower than normal number of red blood cells.
The clots can limit or block the flow of oxygen-rich blood to the body’s organs, such as the brain, kidneys, and heart. As a result, serious health problems can develop.
The increased clotting that occurs in TTP also uses up platelets (PLATE-lets) in the blood. Platelets are blood cell fragments that help form blood clots. These cell fragments stick together to seal small cuts and breaks on blood vessel walls and stop bleeding.
With fewer platelets available in the blood, bleeding problems can occur. People who have TTP may bleed inside their bodies, underneath the skin, or from the surface of the skin. When cut or injured, they also may bleed longer than normal.
Bleeding under the skin also can cause tiny red or purple dots on the skin. These pinpoint-sized dots are called petechiae (peh-TEE-kee-ay). Petechiae may look like a rash.
A lack of activity in the ADAMTS13 enzyme (a type of protein in the blood) causes TTP. The ADAMTS13 gene controls the enzyme, which is involved in blood clotting. The enzyme breaks up a large protein called von Willebrand factor that clumps together with platelets to form blood clots.
TTP is a problem with the blood system in which platelets and red blood cells are destroyed at a very rapid rate. Red blood cells are needed to carry oxygen throughout the body. Platelet cells are needed to stop bleeding. For some unknown reason, the immune system begins to destroy its own platelets and red blood cells. This causes symptoms of anemia (low red blood cell count) and bleeding. It may cause the person to experience weakness, fatigue, dizziness, headache and shortness of breath. It may also cause bleeding from the nose and mouth. A small cut may not stop bleeding. Lots of bruises and small red spots on the arms, legs and other body sites may also be noticeable. Some people have confusion. 4-6 our of every million Americans are affected each year.
Treatment is available, but it can be diagnosed early if the necessary blood tests are performed on a regular basis.
External Symptoms

This photograph shows purpura (bleeding) in the skin. Bleeding under the skin causes the purple, brown, and red color of the purpura.
Internal Symptoms
A blood film from a patient with TTP showing relatively minor changes. Platelets are severely reduced and there are occasional red cell fragments (arrowed)




